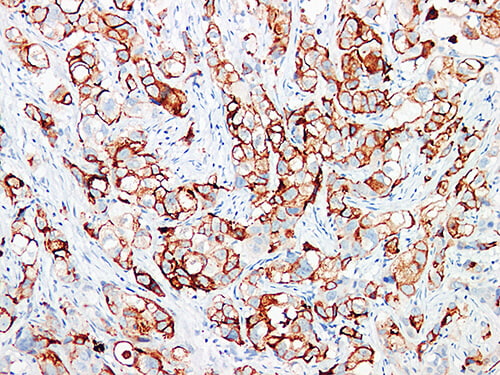

GCDFP-15 Antibody (Immunohistochemistry)
The GCDFP-15 (Gross Cystic Disease Fluid Protein-15) Antibody is a highly specific
immunohistochemical marker used to identify apocrine-differentiated breast carcinomas.
GCDFP-15 is a 15 kDa glycoprotein found in apocrine epithelial cells of the breast ducts, as well as in
the axillary, salivary, vulvar, and eyelid glands.
In pathology, GCDFP-15 shows strong cytoplasmic staining in breast adenocarcinomas.
Meanwhile, it is usually negative in lung, colorectal, and mesothelial tumors.
As a result, GCDFP-15 is extremely valuable for distinguishing metastatic breast carcinoma
from other adenocarcinomas of unknown origin.
🔬 Features and Benefits
- Specific marker for apocrine breast carcinoma
- Clear brown cytoplasmic staining in positive cells
- Useful for identifying breast metastases
- Compatible with standard IHC protocols
- Stable for up to 18 months at 2–8 °C
💡 Diagnostic Applications
- Detection of breast adenocarcinoma and apocrine carcinoma
- Differentiation from lung, colon, and ovarian adenocarcinomas
- Research on apocrine differentiation in neoplastic tissues
🌐 Fardad Azma Rad Co.
Fardad Azma Rad Co., the exclusive representative of
Talent Biomedical in Iran, supplies high-quality IHC antibodies including
GCDFP-15. The company is committed to diagnostic accuracy, scientific precision,
and international quality standards, supporting pathology laboratories across the country.

There are no reviews yet.